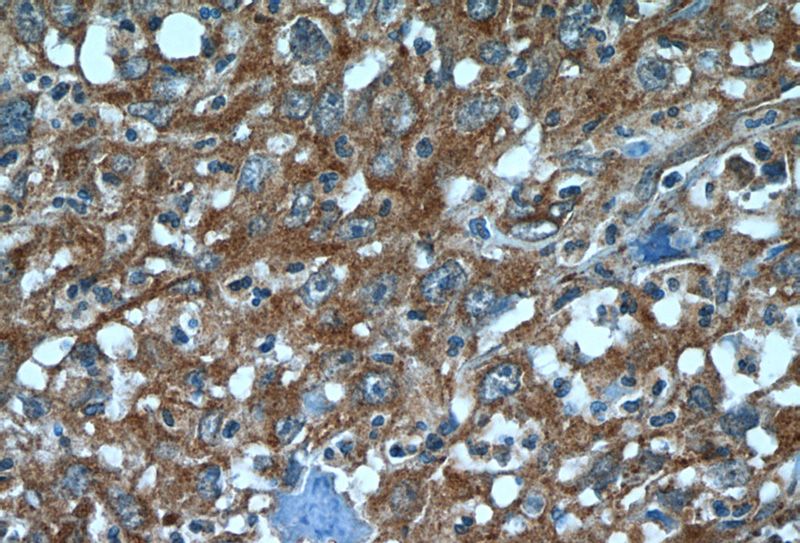
Immunohistochemistry of paraffin-embedded human cervical cancer tissue slide using Catalog No:108286(ATF6 Antibody) at dilution of 1:50 (under 40x lens)

-
Product Name
ATF6 antibody
- Documents
-
Description
ATF6 Rabbit Polyclonal antibody. Positive IP detected in HeLa cells. Positive WB detected in MCF-7 cells, HeLa cells, mouse liver tissue. Positive IF detected in HeLa cells. Positive IHC detected in human cervical cancer tissue, human pancreas tissue. Observed molecular weight by Western-blot: 90 kDa
-
Tested applications
ELISA, WB, IF, IHC, IP
-
Species reactivity
Human, Rat, Mouse; other species not tested.
-
Alternative names
ATF6 antibody; ATF6 alpha antibody; ATF6A antibody
-
Isotype
Rabbit IgG
-
Preparation
This antibody was obtained by immunization of ATF6 recombinant protein (Accession Number: BC014969). Purification method: Antigen Affinity purified.
-
Clonality
Polyclonal
-
Formulation
PBS with 0.02% sodium azide and 50% glycerol pH 7.3.
-
Storage instructions
Store at -20℃. DO NOT ALIQUOT
-
Applications
Recommended Dilution:
WB: 1:1000-1:10000
IP: 1:500-1:5000
IHC: 1:20-1:200
IF: 1:10-1:100
-
Validations

MCF-7 cells were subjected to SDS PAGE followed by western blot with Catalog No:108286(ATF6 Antibody) at dilution of 1:3000

IP Result of anti-ATF6 (IP:Catalog No:108286, 4ug; Detection:Catalog No:108286 1:1500) with HeLa cells lysate 2800ug.
Immunohistochemistry of paraffin-embedded human cervical cancer tissue slide using Catalog No:108286(ATF6 Antibody) at dilution of 1:50 (under 40x lens)

Immunofluorescent analysis of HeLa cells using Catalog No:108286(ATF6 Antibody) at dilution of 1:25 and Rhodamine-Goat anti-Rabbit IgG
-
Background
Activating transcription factor 6 (ATF6) is a transcription factor that acts during endoplasmic reticulum stress by activating unfolded protein response target genes. Binds DNA on the 5'-CCAC[GA]-3'half of the ER stress response element (ERSE) (5'-CCAAT-N(9)-CCAC[GA]-3') and of ERSE II (5'-ATTGG-N-CCACG-3'). Binding to ERSE requires binding of NF-Y to ERSE. Could also be involved in activation of transcription by the serum response factor.During unfolded protein response an approximative 50 kDa fragment containing the cytoplasmic transcription factor domain is released by proteolysis. The cleavage seems to be performed sequentially by site-1 and site-2 proteases. The fully glycosylated form of ATF6, a 670 amino acid protein, exhibits an electrophoretic mobility of ~90 kDa in denaturing SDS-gels, in part because of the glycosylated modifications. ATF6 has 3 consensus sites for N-linked glycosylation and exists constitutively as a glycosylated protein. Differentially glycosylated ATF6 forms may result from mutations or experimental treatment (PMID:15804611) (PMID:14699159). The antibody recognizes cleaved and fully glycosylated forms of ATF6.
-
References
- Yu H, Zheng L, Xu L. Potent effects of the total saponins from Dioscorea nipponica Makino against streptozotocin-induced type 2 diabetes mellitus in rats. Phytotherapy research : PTR. 29(2):228-40. 2015.
- Xu D, Su C, Song X. Polychlorinated biphenyl quinone induces endoplasmic reticulum stress, unfolded protein response, and calcium release. Chemical research in toxicology. 28(6):1326-37. 2015.
- Lin Y, Zhuang J, Li H. Vaspin attenuates the progression of atherosclerosis by inhibiting ER stress‑induced macrophage apoptosis in apoE‑/‑ mice. Molecular medicine reports. 13(2):1509-16. 2016.
Related Products / Services
Please note: All products are "FOR RESEARCH USE ONLY AND ARE NOT INTENDED FOR DIAGNOSTIC OR THERAPEUTIC USE"
